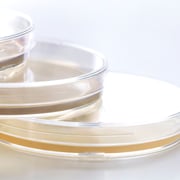
AC Plates

Air Sampling in Food Manufacturing: Active and Passive Monitoring for Contamination Control
How risk-based air monitoring supports zoning verification, trend analysis, and stronger EM...
AnalytiChem is an official distributor of Spectral Blue® in the United Kingdom, France, Germany, and the Benelux region. This partnership expands access to Spectral Blue’s chemical-free, visible blue light disinfection technology for organizations operating in regulated and hygiene-critical environments.
Spectral Blue MWHI® uses patented multi-wavelength blue light to provide automated, continuous microbial control in cleanrooms, laboratories, and food production environments. Allowing you to reduce your dependency on current harmful UV and chemicals decontamination solutions.
In GMP cleanrooms, microbiology laboratories, and food processing facilities, contamination control is constant, complex, and costly. Traditional disinfection methods rely heavily on chemicals, manual processes, or UV systems that cannot operate safely in occupied spaces.
Spectral Blue MWHI® introduces a new approach: automated, continuous disinfection using visible blue light that works safely in real-world operational environments.
This technology adds a persistent layer of microbial control that supports existing hygiene protocols, reduces risk, and improves consistency.
Spectral Blue devices use Multi-Wavelength High-Intensity (MWHI®) dual antimicrobial blue‑light wavelengths 405 and 430–470 nm to deliver faster, broader, and more energy‑efficient disinfection than single‑wavelength systems.
Many microbes naturally contain light-sensitive molecules such as porphyrins and flavins. When exposed to specific blue light wavelengths, these molecules generate reactive oxygen species (ROS) inside the microbial cell.
This process damages essential cellular structures and leads to microbial inactivation. Key Characteristics:
Visible blue light (not UV)
Safe for use around people
No chemical residues
No ozone or mercury
Compatible with sensitive materials and equipment
Effective against bacteria, yeasts, molds, viruses, and biofilms
Backed by peer-reviewed research and independent laboratory testing, blue light disinfection is increasingly recognized as a powerful complement to traditional hygiene practices.
The Limits of Episodic Cleaning
Manual cleaning and chemical disinfection are essential, but their effects are temporary. Microbial levels can rebound between cleaning cycles, particularly in high‑traffic or sensitive areas. Chemical use can also leave residues that promote dry biofilm formation, create material compatibility issues, increase operator exposure, and raise environmental and ESG concerns.
Continuous Blue Light Control
Spectral Blue operates automatically during off‑hours or around the clock, continuously reducing microbial load on surfaces, in the air, and on equipment. This supports a more stable contamination control strategy by reducing deviation risk, improving consistency, lowering chemical reliance, and strengthening sustainability performance.
Spectral Blue offers multiple device formats to match different spaces and workflows.


Ideal for: Biosafety cabinets and laminar flow hoods


Ideal for: Benches, walls, and smaller rooms


Ideal for: Flexible room disinfection
Mobile, self-standing design
Quick deployment where needed


Ideal for: Whole-room coverage
Broad area treatment
Suitable for larger controlled spaces
| Model | Ideal Use | Placement | Coverage Style |
| SALO / SALO XL | Cabinets & hoods | Internal | Targeted |
| OSLO | Benches & walls | Fixed | Directional |
| BERLIN | Rooms | Mobile | Flexible |
| HELSINKI | Whole rooms | Mobile | 360º |
Cleanroom contamination often originates in boundary areas such as gowning rooms, material airlocks, and transfer zones. These areas represent a critical control point for protecting production environments.
Spectral Blue provides automated microbial reduction in these high-risk zones without disrupting workflows. Benefits for Cleanrooms:
Continuous reduction of surface and airborne microbes
Reduced contamination transfer between zones
Lower reliance on chemical disinfectants
Supports GMP contamination control strategies
Operates safely in real facilities
Typical installation areas include gowning rooms, material flow zones and material airlocks, as well as biosafety cabinets, filling machines, and transfer corridors.

Download the flyer here
Read testimonials here
Request More InformationMicrobiology and Life Science Laboratories
Laboratories demand reliable hygiene without compromising safety, instruments, or results. Unlike UV systems, Spectral Blue visible light can be used safely in occupied environments and does not degrade plastics or sensitive materials. Benefits for Laboratories:
Reduces background microbial contamination
Helps prevent cross-contamination and false positives
Safe for staff, instruments, and labware
Can replace or supplement UV in cabinets
Supports sustainable lab operations
Common use areas include biosafety cabinets, laminar flow hoods, workbenches, and entire laboratory rooms.

Download the flyer here
Read testimonials here
Request More InformationFood Processing Environments
Food production environments face constant microbial pressure, particularly from Listeria, Salmonella, Campylobacter and E. coli and biofilms. Traditional sanitation remains critical, but continuous hygiene control adds an extra layer of protection.
Spectral Blue supports daily hygiene programs without chemical exposure or production downtime. Benefits for Food Facilities:
Continuous pathogen pressure reduction
Supports brand protection and recall prevention
Safe for staff and materials
Chemical-free operation
Compatible with sustainability goals
Typical applications include processing lines and conveyors, packaging areas, personnel cut‑off rooms, and equipment zones.

Download the flyer here
Read testimonials here
Request More InformationEffective contamination control doesn’t rely on a single tool. The strongest programs combine prevention, monitoring, and validation to maintain consistent hygiene standards and support regulatory compliance.
AnalytiChem works in partnership with customers to build robust contamination control strategies that integrate Spectral Blue automated disinfection with trusted cleaning agents, environmental monitoring and validation tools.
Complementary Hygiene Tools
Pairing Spectral Blue continuous disinfection with cleaning validation reagents, supports hygiene compliance and contamination control workflows.
Our portfolio includes:
Ready-to-use media for reliable microbial testing
Supporting hygiene verification while Spectral Blue provides ongoing microbial reduction in the background.
Surface disinfection is only one part of contamination control, and monitoring airborne microbes is essential in cleanrooms and controlled environments. AnalytiChem provides SAS air samplers, a widely trusted solution for active air monitoring in regulated areas.
They support GMP environmental monitoring programs, deliver reliable airborne microbial detection, and are ideal for cleanrooms, laboratories, and production spaces.
 Trusted Cleaning Agents
Trusted Cleaning Agents
70% IPA (isopropyl alcohol) is commonly used for routine disinfection of surfaces and equipment in controlled environments, while hydrogen peroxide solutions are widely applied in cleanroom and laboratory disinfection protocols.
Spectral Blue helps reduce microbial load, and monitoring and validation tools support the confirmation and documentation of hygiene performance.
Many customers choose to combine Spectral Blue with monitoring tools and consumables to build a more complete contamination control program. Sourcing these elements from a single supplier provides greater operational value, simplified supplier management, consistent hygiene programs, and long‑term partnership support.
Our team works with you to design a practical and scalable solution tailored to your facility and regulatory requirements.
Every facility is different. Spectral Blue planning uses computer simulation-based design to create a 3D plan to determine optimal device type, placement, and coverage. You receive:
Recommended device types and quantities
Suggested placements
Coverage optimization
There’s no obligation to purchase, this service is completely free.

Contact us for your free 3D Disinfection Plan
Request More InformationSpectral Blue supports sustainability goals by reducing dependence on chemicals and disposable products.

No mercury and no ozone
Long-life LEDs
Reduced chemical consumption
Supports ESG targets and safer workplaces
Doesn't generate waste
Spectral Blue’s multi-wavelength blue light technology is already supporting contamination control in cleanrooms, laboratories, food production facilities, and other environments where maintaining strict hygiene is essential.
Below, we highlight feedback from organizations that have implemented Spectral Blue solutions in their facilities. These experiences show how the technology can help lower contamination risk, reduce reliance on chemical disinfectants, enhance workplace safety, and simplify day-to-day hygiene management while supporting more sustainable operations.
Large international pharmaceutical company: Eliminated dry biofilms
Deploying Spectral Blue led to a substantial and persistent reduction of bioburden. The performance of their manual cleaning also improved thanks to blue light.
NextPharma: 90% reduction in contamination
NextPharma installed Spectral Blue in cleanroom boundary areas: an equipment washing room and a material airlock. The system reduced contamination in adjacent production areas by 90%.
Nordic Laboratories
Nordic Laboratories chose Spectral Blue for their biosafety cabinets to safeguard their quality and to protect their staff.
Eurofins Scientific Finland Oy
Eurofins Scientific Finland Oy introduced Spectral Blue in its laboratory to provide continuous, chemical-free disinfection. The system improved hygiene reliability while supporting safer working conditions and simplifying routine laboratory operations.
Large Sushi Producer
Central European manufacturer of Ready-To-Eat sushi meals was able to bring Listeria contamination to zero with Spectral Blue.
Metzgerei Künzli (Switzerland)
Metzgerei Künzli (Switzerland) uses Spectral Blue MWHI® in their food production site to enhance existing hygiene protocols, by safely eliminating microbial residues and biofilms.
Antimicrobial blue light (aBL) is supported by a substantial and growing body of scientific research. More than 2,500 peer-reviewed publications have explored how specific blue light wavelengths can inactivate a wide range of microorganisms.
To help you navigate the evidence, we’ve brought together key scientific review papers along with selected recent publications. These resources summarise the current understanding of antimicrobial blue light and its potential applications in controlled and hygiene-critical environments.
Key Review Articles
The review papers below provide an overview of how antimicrobial blue light interacts with microbial cells and why it is effective across different organisms.
They also compile extensive reference lists covering laboratory studies, real-world applications, and emerging research areas, making them a useful starting point for teams evaluating blue light disinfection technologies.
Leon G. Leanse, Carolina dos Anjos, Sana Mushtaq, Tianhong Dai. Antimicrobial blue light: A ‘Magic Bullet’ for the 21st century and beyond'. Advanced Drug Delivery Reviews 180 (2022) 114057 https://doi.org/10.1016/j.addr.2021.114057
Click here to access the FAQ on the official Spectral Blue website

How risk-based air monitoring supports zoning verification, trend analysis, and stronger EM...

Rare earth element (REE) deposits present some of the most analytically challenging matrices in...

Persistence, biofilms, and what it takes to build a monitoring program that works.